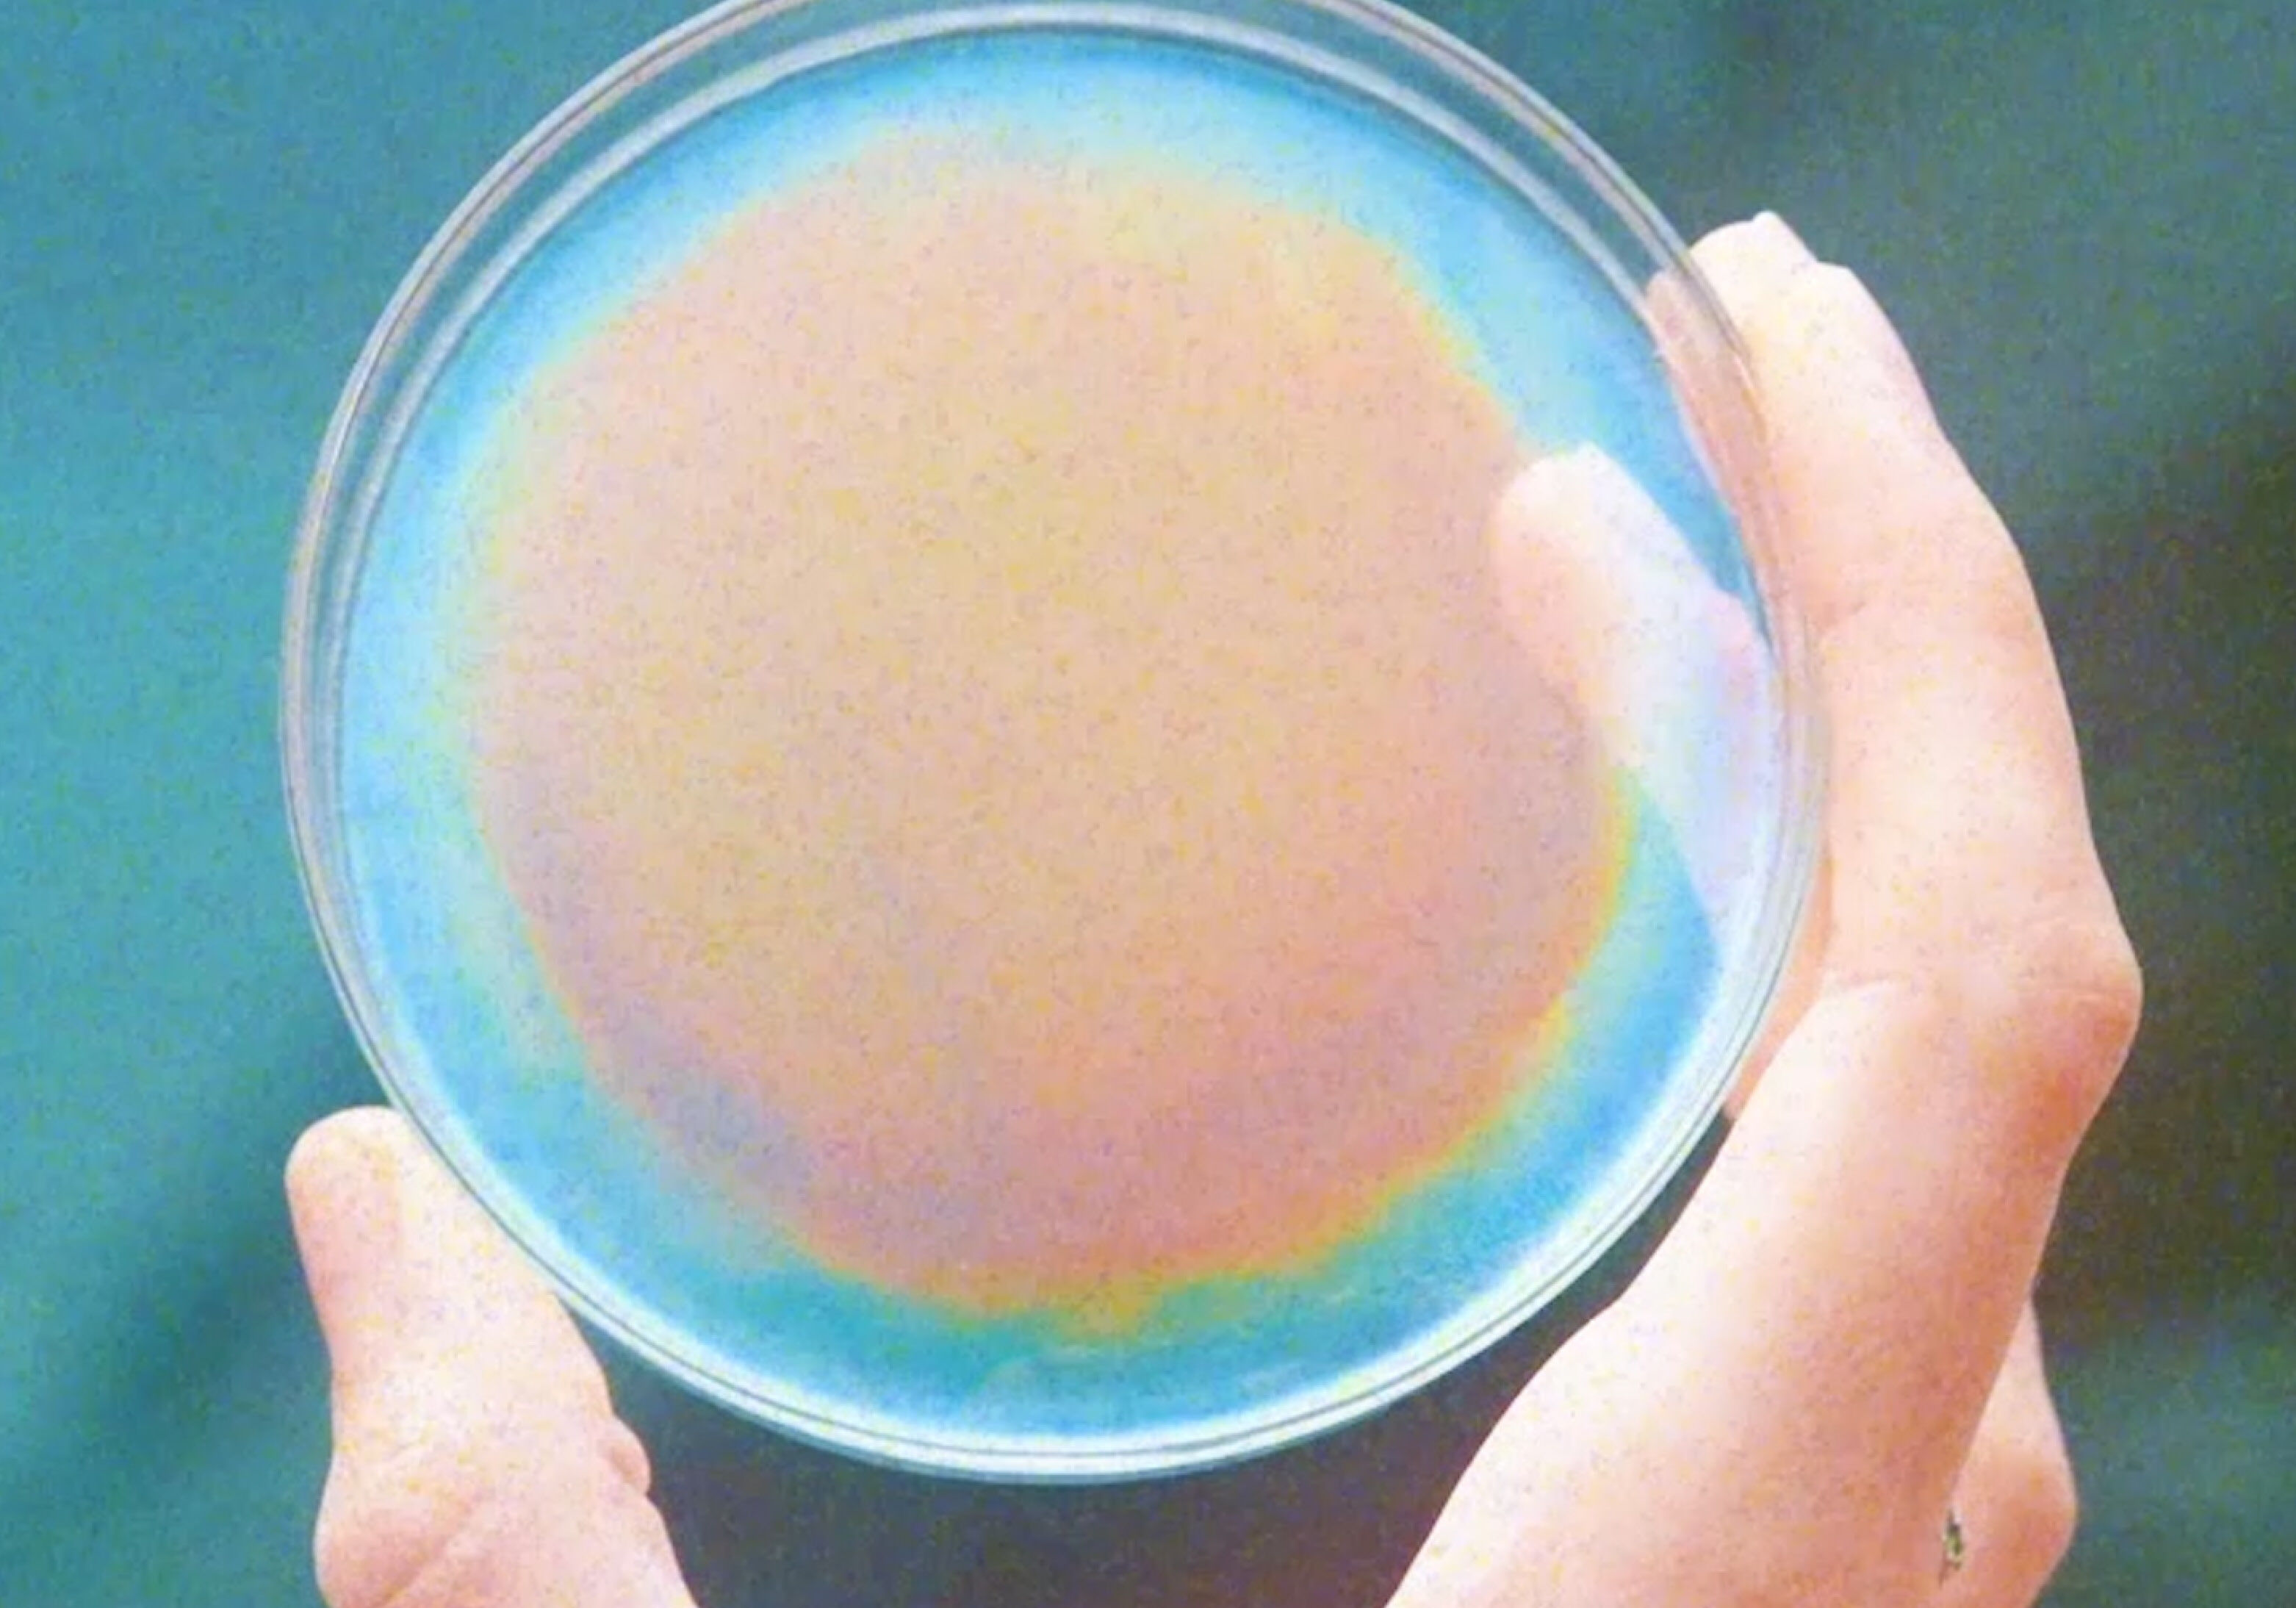

Sustainable sparkle by Radiant Matter, the innovators of BioSequin
Radiant Matter engineers bio-inspired and structurally coloured materials for the circular economy. Its innovations are non-toxic, biodegradable and low carbon, without the use of plastics, metals, minerals or pigments – including BioSequins, which Stella McCartney made world-first garments with.
British women purchase 33 million sequinned garments every festive season, with 1.7 million ending up in landfill after only 5 years and 35% of microplastics being released into the world’s oceans. These conventional sequins are made of polyester film or vinyl, which involve toxic and carcinogenic chemicals that cause significant environmental and health risks.
BioSequins are a plastic-free, biodegradable and non-toxic sequin alternative, innovated from plant-derived cellulose, using no metals, minerals or synthetic pigments or colourants. In April 2023, Stella McCartney debuted the world’s first sustainably sparkling, BioSequin-embroidered garment – an all-in-one, photographed by the legendary Annie Leibovitz and worn by model, eco-activist and House friend, Cara Delevigne.
Why are sequins bad for the environment?
Although they are small, the collective impact of sequins is massive. Most sequins are tiny synthetic-coated or metallic-foiled disks comprised of petroleum-based microplastics. Widely used within all sectors of fashion, textiles and consumer goods, they constantly leak into our environment, causing problems to both us and our planet.
What are BioSequins?
BioSequins are a sparkling sustainable material that can revolutionise the fashion industry at its core. Intending to shift the textile industry's dependence on this shiny problem, Radiant Matter’s BioSequins aim to reduce microplastic pollution by keeping our oceans and waterways clean, while providing high-performance, sustainable and environmentally friendly colour effects.
How are BioSequins made?
Formed from infinitely renewable cellulose derived from plants, BioSequins brilliantly shimmer in a multitude of non-toxic, colourfast and pigment free palettes. Even the metallic sheen is free from minerals, metals and associated mining.
Radiant Matter not only offers a completely ethical sequin supply chain, but a completely sustainable sparkle, too.